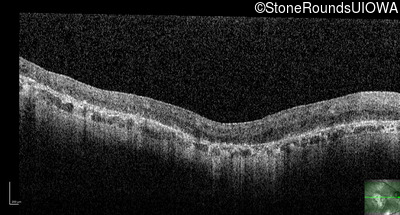
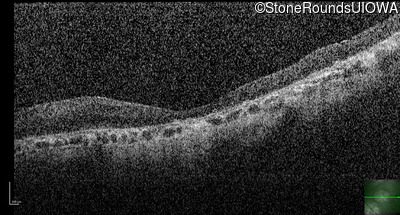
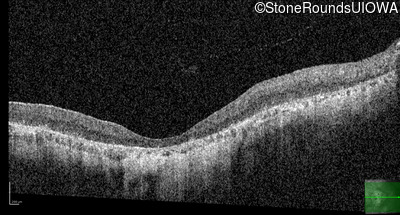

SR1187
Type 2 Usher Syndrome (IB1b)
Male
Male
SR1187
Type 2 Usher Syndrome (IB1b)
Male
Male
| Age at visit: 76 years |
| Age at visit: 77 years |
| Age at visit: 78 years |
| Age at visit: 81 years |
| Age at visit: 83 years |
Diagnosis & molecular findings
| Disease | Gene | Allele 1 variant(s) | Allele 2 variant(s) | Inheritance mode |
|---|---|---|---|---|
| Type 2 Usher Syndrome | ARSG | Arg95Gln CGG>CAG | Ala234 ins1gC | AR |
Disease:
Gene:
Allele 1:
Arg95Gln CGG>CAG
Allele 2:
Ala234 ins1gC
Inheritance:
AR